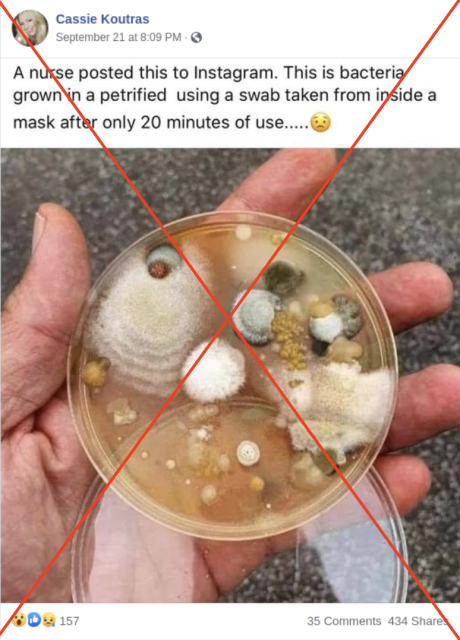
Screenshot Facebook

Evo šta se taloži na unutrašnjoj strani maske ako je ne menjate
Ako ne perete pamučnu masku posle svakodnevnog nošenja, ili ne menjate redovno hiruršku masku, preti vam zaraza od patogenih mikroorganizama
U septembru je Facebook-om počela da kruži fotografija Petrijeve šolje sa kolonijama bakterija koje su tu razmnožile navodno iz brisa uzetog sa unutrašnjosti hirurške maske koja je nošena samo 20 minuta. Međutim, vrlo brzo su se oglasili mikrobiolozi sa činjenicama da je tim bakterijama potrebno dosta vremena da se razmnože u tim količinama, kao i da su u uzorku očigledno prisutni i mikrobi kojih inače nema u izdahnutom vazduhu, kao i da je posuda očigledno veoma dugo stajala na vazduhu jer je kontaminirana gljivicama.
Maske važne
Iako je ova senzacionalistička objava očigledno pogrešna, to nikako ne znači da ne treba da nosite maske tokom pandemije. Nošenje maski je obavezno u zatvorenim prostorima, a preporuka je da se nose i na otvorenom u situacijama kada se stvaraju gužve (npr. pešački prelaz).
Screenshot obmanjujućeg post-a na Facebook-u
U našim ustima živi preko 700 vrsta bakterija i gljivica, ali većina je potpuno bezazlena, a čak su neke i veoma važne za naše zdravlje i deo su „normalne flore“ našeg digestivnog trakta. Količina bakterija u ustima, pogotovo onih patogenih – koje izazivaju bolesti, zavisi naravno od stepena oralne higijene. Najveći broj tih bakterija čine streptokoke. Od gljivica je tu najčešća kandida, a od virusa herpes. Ti mikororganizmi se sa svakim izdahom izbacuju i naravno „lepe“ za unutrašnjost maske koju nosimo.
Menjajte ili perite masku
Kako još izdahnutim vazduhom vlažimo masku, time stvaramo i idealne uslove za razmnožavanje svih mikroorganizama. Ali u tim količinama koje se izdahnu tokom dana, ti mikroorganizmi nisu opasni po naše zdravlje – što je i logično, upravo te količine smo i izbacili iz sopstvenog tela. Međutim, ukoliko dozvolimo bakterijama da se namnože, onda smo u problemu.
Dakle, hirurške maske se bacaju nakon svakog nošenja, a pamučne moraju da se peru svaki dan. To je sasvim dovoljno da sprečimo razvoj bakterija na maskama.
Važno je i kako je čuvamo između dva nošenja
Ovde bismo dodali i da maske mogu da se kontaminiraju i drugim bakterijama iz spoljašnje sredine, ako ih nepropisno odlažemo između nošenja – u tašni, džepu, na stolu. Tako da moramo da vodimo računa i o tome da ne prljamo masku kada je skinemo ukoliko ćemo je opet stavljati na lice. Masku je najbolje preklopiti sa unutrašnjom stranom ka unutra, i odložiti je u neku čistu kesicu.
eKlinika zadržava sva prava nad sadržajem. Za preuzimanje sadržaja pogledajte uputstva na stranici Uslovi korišćenja.


momcilo
Svi mi dobro znamo da masku upotrebimo jedanput ali nismo svi umogucnosi da kupimo toliko maski.to je razlog sto se maska nosi fok nebude garava od prljavstine.
Podelite komentar